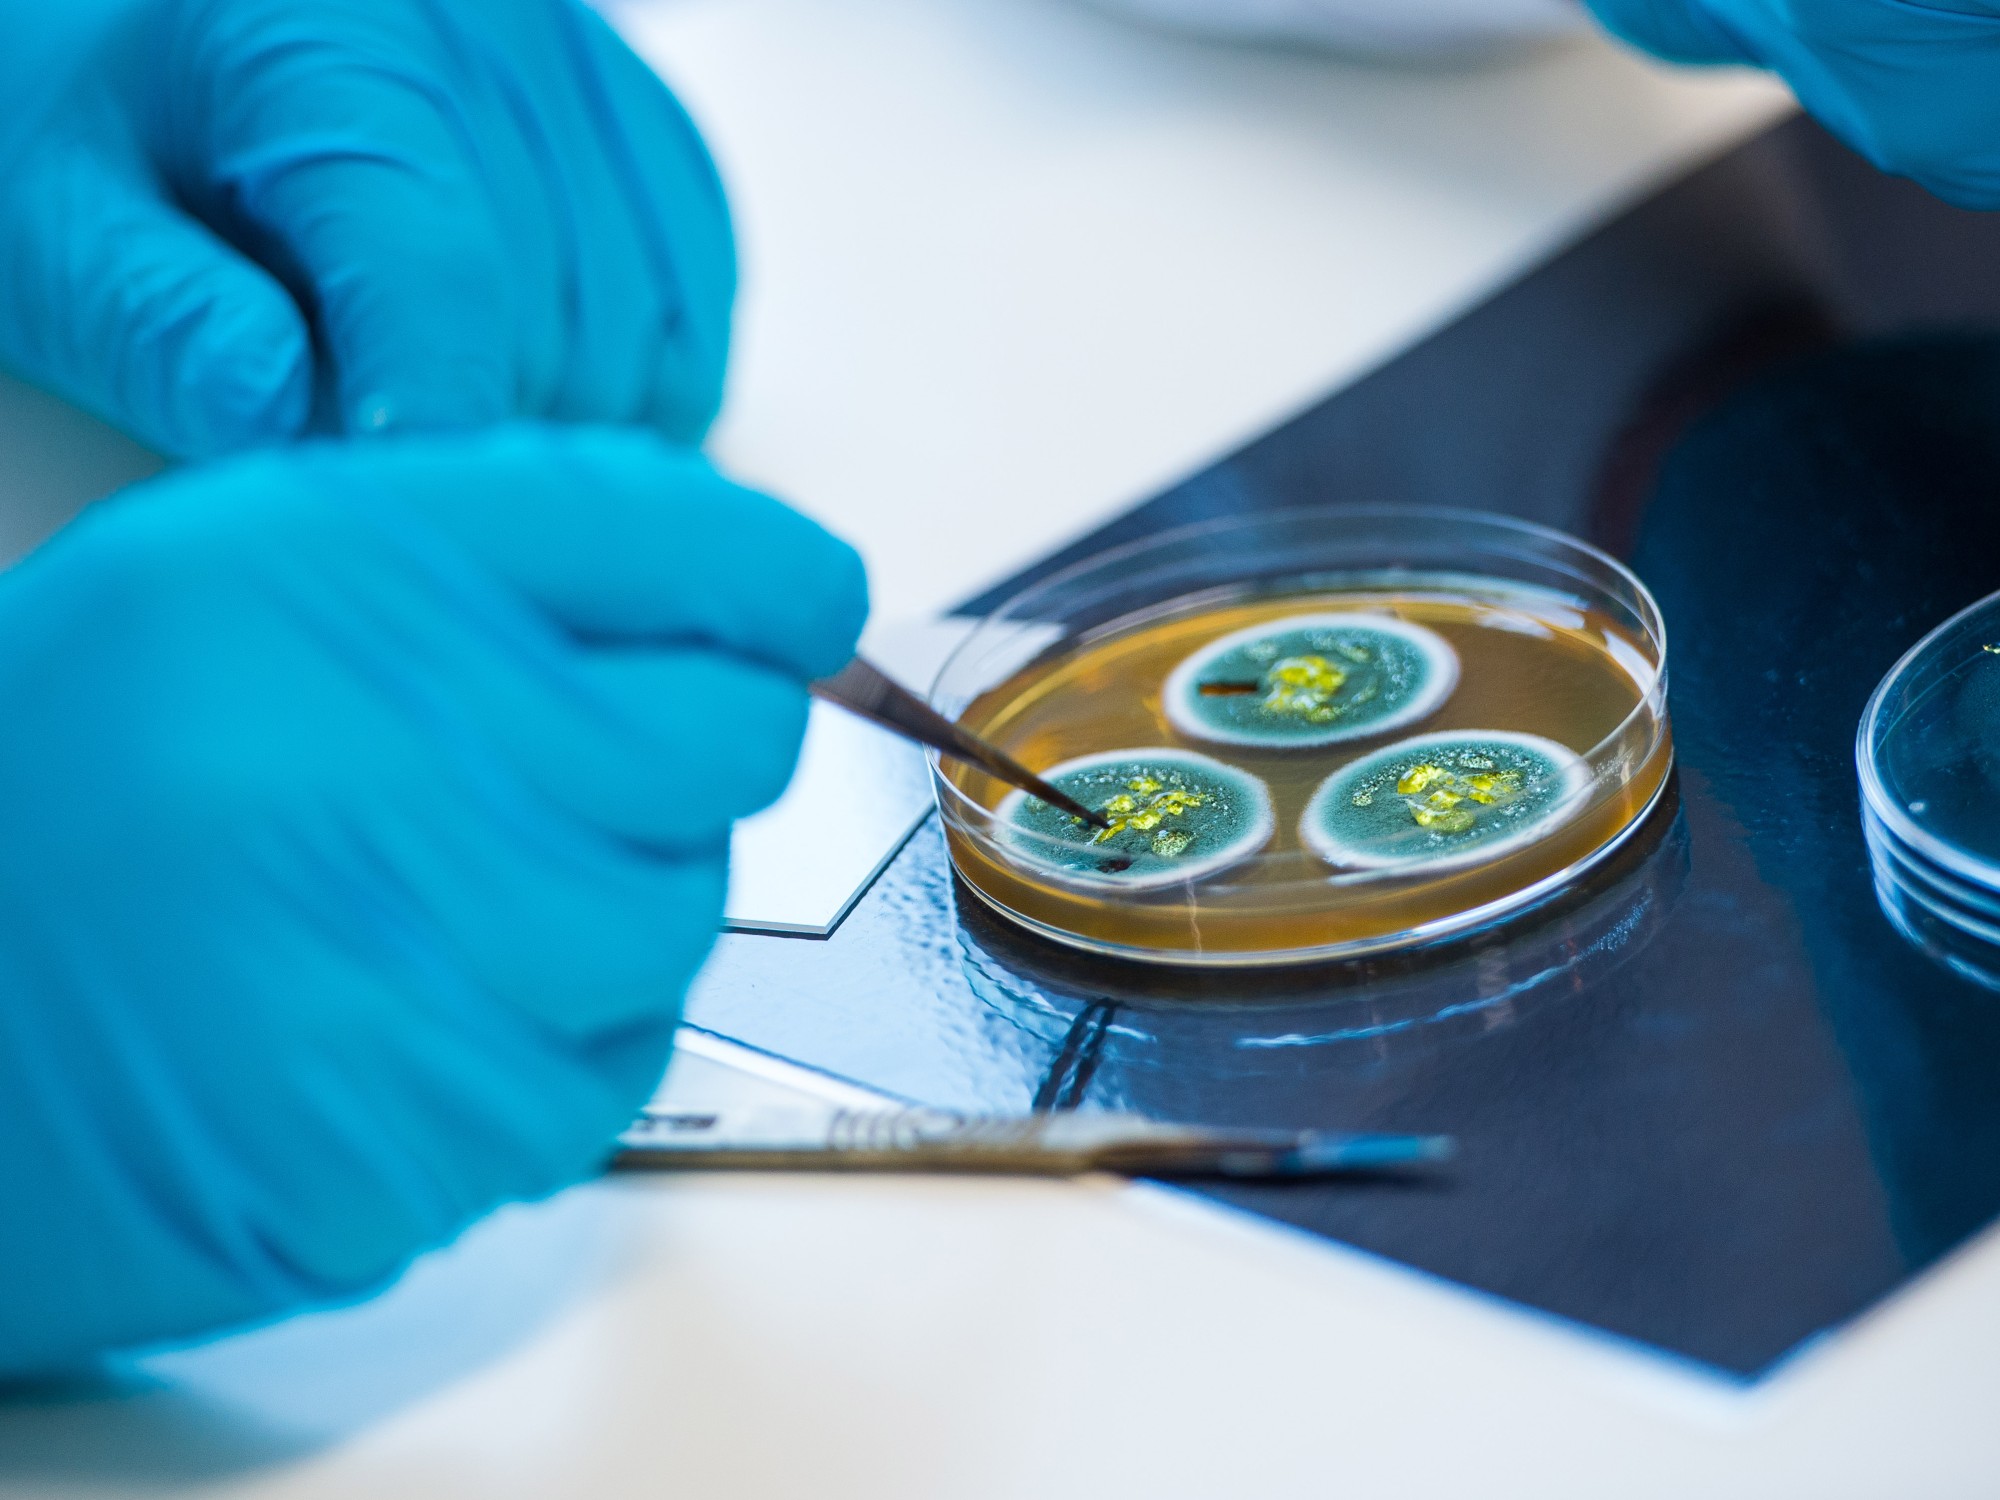

- Biosciences and Medicine
MD Biosciences and Medicine
Our Biosciences and Medicine MD will give you the chance to contribute to a fast-paced area of research that's becoming increasingly relevant to modern society. Develop your area of research and work alongside world-leading researchers who are published in established clinical academic journals, including the BMJ, Nature and The Lancet.
4,138+ people have created a bespoke digital prospectus
Why choose this
programme?
- Champion our ‘One Health, One Medicine' approach, which brings together expertise from a broad range of multidisciplinary areas.
- Complete a combination of research and clinical practice over a period of two to three years (full-time) or four to six years (part-time).
- Embrace a ‘bench to bedside’ philosophy, with the potential to take part in molecular and computational studies as well as clinical trials.
Statistics
100%
Of our biosciences research graduates are in employment or further education (Graduate Outcomes 2025, HESA)
Top 20 for research outputs
The University of Surrey is ranked in the top 20 for the quality of our research outputs (REF 2021)
33rd for overall research quality
The University's overall research quality ranking has risen by 12 places to 33rd in the UK (REF 2021)
What you will study
Depending on your research project, you’ll likely complete a clinically orientated project to generate data that will underpin your final thesis. Some research areas will be primarily or entirely related to the analysis of existing scientific or clinical data sets; however, all projects will require some statistical analysis. Some projects will be conducted at Surrey, whereas others will involve collaboration with other institutions.
Our current students are researching topics including:
- Combining multi-omic data analysis methods to increase understanding of key diseases, such as diabetes and cancer
- Computational approaches to modelling biological systems
- Developing the molecular and physiological bases of circadian rhythms, sleep, immunity and cardiovascular disease
- Improving the detection of colorectal cancer
- Optimising perioperative support.
Assessment
Your final assessment will be based on the presentation of your research in a written thesis, which will be discussed in a viva examination with at least two examiners.
You have the option of preparing your thesis as a monograph (one large volume in chapter form) or in publication format (including chapters written for publication), subject to the approval of your supervisors.
You’ll have a confirmation assessment to formally review your project. If you're a full-time student, this will take place around 9-12 months into your studies or 18-24 months if you’re studying part-time. You’ll be required to submit a written report and successfully complete an oral examination.
Location
This course is based at Stag Hill campus. Stag Hill is the University's main campus and where the majority of our courses are taught.
Research themes
Our vibrant community of researchers are playing a pivotal role within their fields of research. We’re investigating areas including:
- Bacteriology
- Cardiovascular sciences
- Chronobiology
- Cancer
- Critical care
- Diabetes
- Laparoscopic surgery
- Primary care and clinical informatics
- Metabolic medicine, food and macronutrients
- Statistical multi-omics
- Systems biology.
Research centres and institutes
You’ll be supported by at least two supervisors from the School of Biosciences. Your supervisors will have scientific expertise relevant to your research project and will provide academic and pastoral support throughout your studies.
Supervisors may include:
Research support
The professional development of postgraduate researchers is supported by the Doctoral College, which provides training in essential skills through its Researcher Development Programme of workshops, mentoring and coaching. A dedicated postgraduate careers and employability team will help you prepare for a successful career after the completion of your PhD.
Progress reviews
In addition to the confirmation process, you’ll have six-monthly progress reviews with your supervisors. These meetings are an opportunity to reflect on your progress, discuss successes and challenges and set targets for the next six months. These reviews will be monitored by postgraduate research directors and recorded on your student record.
You’ll also have one formal meeting with your supervisors every month and can expect to have more frequent meetings between these. The regularity of these will depend on the nature and stage of your project.
Facilities
The School of Biosciences is home to world-class specialist facilities.
If you’re looking to research clinical sciences and human physiology, you’ll conduct your research in:
- Surrey Clinical Research Facility
- Surrey Human Performance Institute.
You might also use facilities at the nearby Royal Surrey County Hospital.
If you’re a molecular and cellular science researcher, you can use our facilities in:
- Bioimaging and flow cytometry
- Bioinformatics
- Metabolomics
- Phenomics
- Stable isotope-based analysis
- Transcriptomics.
UK qualifications
Applicants are expected to be registered with the General Medical Council and working within the NHS or in an approved institution.
English language requirements
IELTS Academic: 6.5 or above (or equivalent) with 6 in each individual category.
These are the English language qualifications and levels that we can accept.
If you do not currently meet the level required for your programme, we offer intensive pre-sessional English language courses, designed to take you to the level of English ability and skill required for your studies here.
Selection process
Selection is based on applicants:
- Meeting the expected entry requirements and providing all relevant documents including a satisfactory research proposal
- Being shortlisted through the application screening process
- Completing a successful interview
- Providing suitable references.
Fees per year
Explore UKCISA's website for more information if you are unsure whether you are a UK or overseas student. View the list of fees for all postgraduate research courses.
* Please note: any start date other than September will attract a pro-rata fee for that year of entry (75 per cent for January, 50 per cent for April and 25 per cent for July).
July 2026 - Full-time
- UK
- To be confirmed
- Overseas
- To be confirmed
July 2026 - Part-time
- UK
- To be confirmed
- Overseas
- To be confirmed
October 2026 - Full-time
- UK
- To be confirmed
- Overseas
- To be confirmed
October 2026 - Part-time
- UK
- To be confirmed
- Overseas
- To be confirmed
January 2027 - Full-time
- UK
- To be confirmed
- Overseas
- To be confirmed
January 2027 - Part-time
- UK
- To be confirmed
- Overseas
- To be confirmed
April 2027 - Full-time
- UK
- To be confirmed
- Overseas
- To be confirmed
April 2027 - Part-time
- UK
- To be confirmed
- Overseas
- To be confirmed
- Annual fees will increase by 4% for each year of study, rounded up to the nearest £100 (subject to legal requirements).
Additional costs
There are additional costs that you can expect to incur when studying at Surrey.
Funding
A Postgraduate Doctoral Loan can help with course fees and living costs while you study a postgraduate doctoral course.
Application process
Applicants should contact potential supervisors before submitting an application via the website. Please refer to section two of our application guidance.
After registration
Students are initially registered for a PhD with probationary status and, subject to satisfactory progress, subsequently confirmed as having PhD status.
About the University of Surrey
Need more information?
Contact our Admissions team or talk to a current University of Surrey student online.
Code of practice for research degrees
Surrey’s postgraduate research code of practice sets out the University's policy and procedural framework relating to research degrees. The code defines a set of standard procedures and specific responsibilities covering the academic supervision, administration and assessment of research degrees for all faculties within the University.
Download the code of practice for postgraduate research admissions (PDF).
Terms and conditions
When you accept an offer to study at the University of Surrey, you are agreeing to follow our policies and procedures, student regulations, and terms and conditions.
We provide these terms and conditions at the offer stage and are shown again at registration. You will be asked to accept these terms and conditions when you accept the offer made to you.
View our generic registration terms and conditions (PDF) for the 2025/26 academic year, as a guide on what to expect.
Disclaimer
This online prospectus has been published in advance of the academic year to which it applies.
Whilst we have done everything possible to ensure this information is accurate, some changes may happen between publishing and the start of the course.
It is important to check this website for any updates before you apply for a course with us. Read our full disclaimer.













